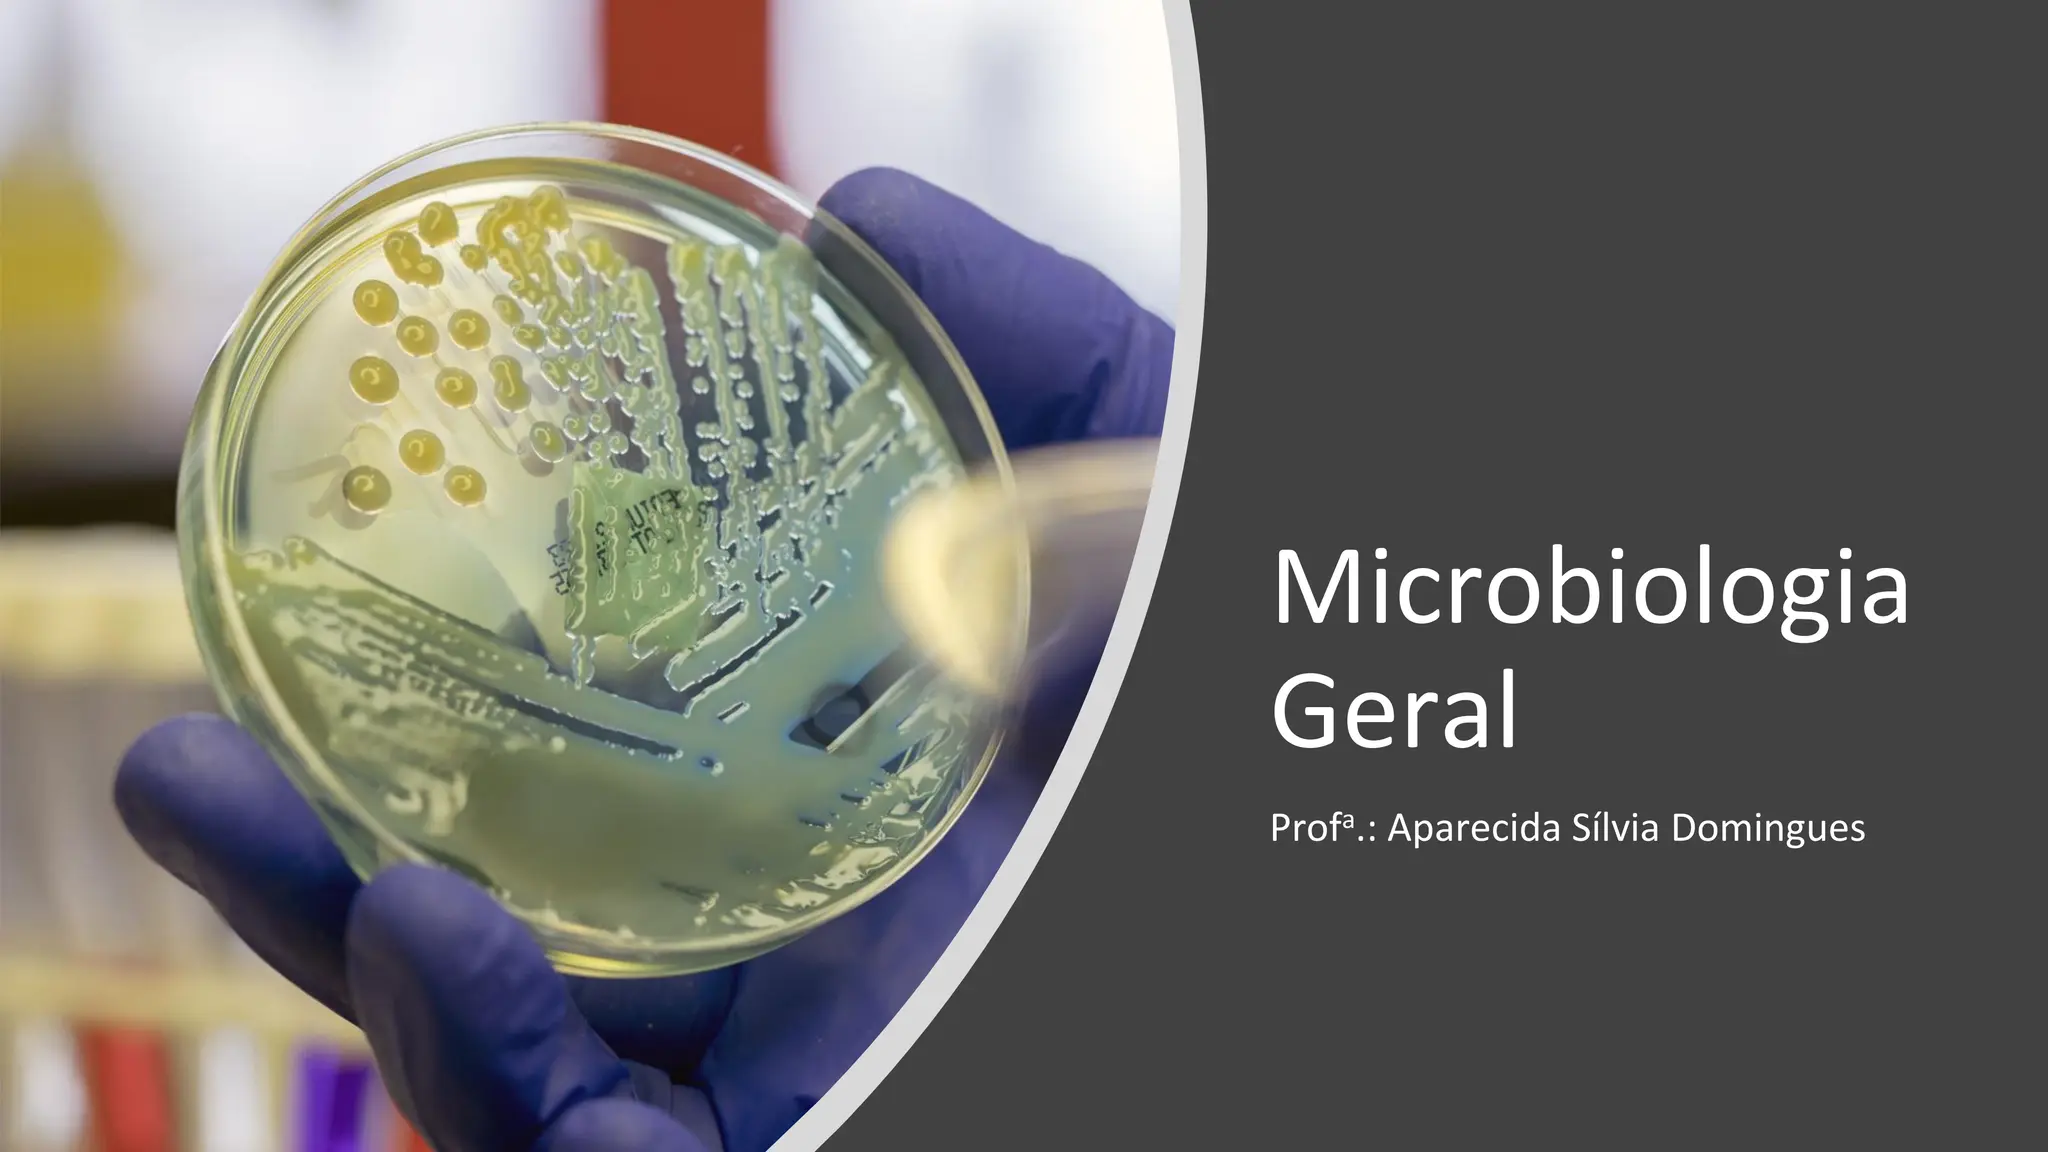
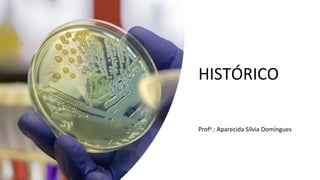
HISTÓRICO
Profa.: Aparecida Sílvia Domingues

O documento aborda a história da microbiologia, destacando as contribuições de figuras chave como Hooke, Leeuwenhoek, Pasteur e Koch, além de discutir a transição entre a geração espontânea e a biogênese. Ele delineia cinco períodos importantes na microbiologia, que incluem a descoberta do microscópio, teorias sobre a origem da vida, e os fundamentais postulados de Koch sobre doenças. Também menciona o impacto de descobertas modernas, como a penicilina e a biotecnologia no campo da microbiologia.